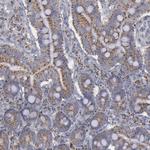
MYOM2 Antibody in Immunohistochemistry (Paraffin) (IHC (P))

Search
Invitrogen
MYOM2 Polyclonal Antibody
{{$productOrderCtrl.translations['antibody.pdp.commerceCard.promotion.promotions']}}
{{$productOrderCtrl.translations['antibody.pdp.commerceCard.promotion.viewpromo']}}
{{$productOrderCtrl.translations['antibody.pdp.commerceCard.promotion.promocode']}}: {{promo.promoCode}} {{promo.promoTitle}} {{promo.promoDescription}}. {{$productOrderCtrl.translations['antibody.pdp.commerceCard.promotion.learnmore']}}
产品信息
PA5-51632
种属反应
宿主/亚型
分类
类型
抗原
偶联物
形式
浓度
规格
纯化类型
保存液
内含物
保存条件
运输条件
RRID
产品详细信息
Immunogen sequence: STQASSQKSL SQRSSSQRAS SQTSLGGTIC RVCAKRVSTQ EDEEQENRSR YQSLVAAYGE AKRQRFLSEL AHLEEDVHLA RSQARDKLDK YAIQQMMEDK LAWERHTFEE RISRAPEILV RLRSHTVWER MSVKLCFTVQ GF
Highest antigen sequence identity to the following orthologs: Mouse - 75%, Rat - 71%.
靶标信息
The giant protein titin, together with its associated proteins, interconnects the major structure of sarcomeres, the M bands and Z discs. The C-terminal end of the titin string extends into the M line, where it binds tightly to M-band constituents of apparent molecular masses of 190 kD and 165 kD. The predicted MYOM2 protein contains 1,465 amino acids. Like MYOM1, MYOM2 has a unique N-terminal domain followed by 12 repeat domains with strong homology to either fibronectin type III or immunoglobulin C2 domains. Protein sequence comparisons suggested that the MYOM2 protein and bovine M protein are identical. [provided by RefSeq, Jul 2008].
仅用于科研。不用于诊断过程。未经明确授权不得转售。
篇参考文献 (0)
生物信息学
蛋白别名: 165 kDa connectin-associated protein; 165 kDa titin-associated protein; M-band protein; M-protein; myomesin (M-protein) 2, 165kDa; Myomesin family member 2; Myomesin-2; titin-associated protein, 165 kD; unnamed protein product
基因别名: MYOM2; TTNAP
UniProt ID: (Human) P54296
Entrez Gene ID: (Human) 9172